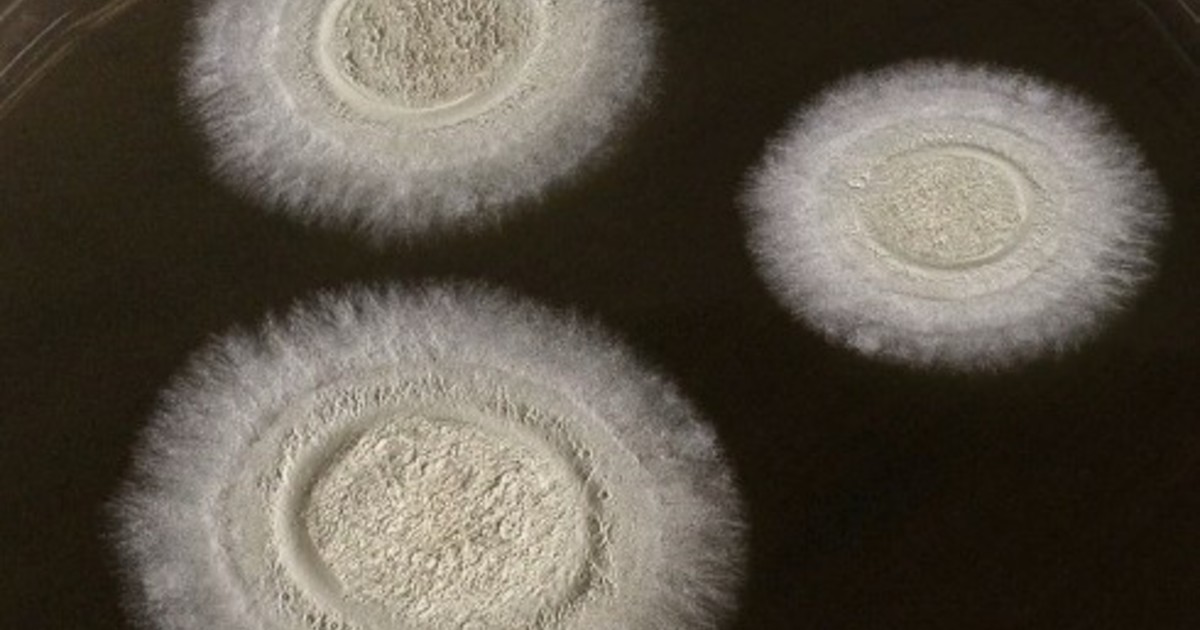

- El precio de la carne vacuna aumentó 33 por ciento en lo que va del año.
- El consumo aparente por habitante cayó 11 por ciento en los últimos doce meses.
- No se vislumbra una recuperación de la capacidad de pago de la población.





Ocupó el cargo por dos años e impulsó la producción y venta de vehículos híbridos y eléctricos. Ex jugador de las inferiores de Huracán, en diez años tuvo una carrera meteórica en la automotriz alemana.